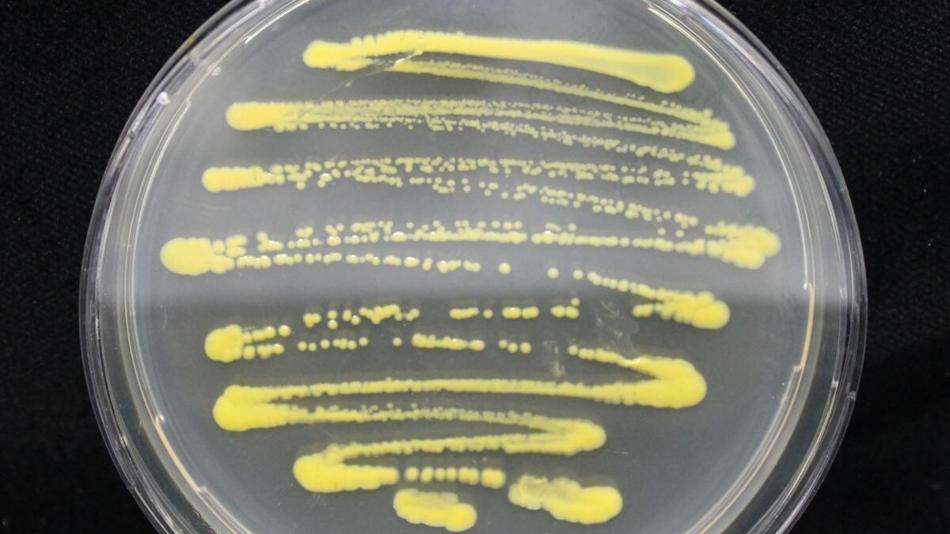
Petrischale mit gelben Bakterien

Mitmachstation
Die Farben der Natur – Ist Rot gleich Rot und Gelb gleich Gelb?
Warum leuchten Weihnachtssterne nie blau und Usambaraveilchen nicht rot? Warum erstrahlen manche Blüten in kräftigem Orange und Bakterien gelb? Und wie entsteht aus „Blau“kraut durch einen Schuss Essig plötzlich „Rot“kraut? Tauchen Sie ein in die faszinierende Welt der Naturfarben und erfahren Sie, warum Rot nicht gleich Rot und Gelb nicht gleich Gelb ist. Werfen Sie mit uns einen faszinierenden Blick durchs Mikroskop und entdecken Sie, wo in der Zelle die Farbstoffe verborgen sind. Wir geben Einblicke in unsere aktuellen Forschungsprojekte „DyeAnotherWay“ (anders färben) und „Wiener Farben“ und öffnen damit ein Fenster in die Zukunft nachhaltiger Farbproduktion: Wir untersuchen Farbstoffe aus Pflanzen und Bakterien, die eines Tages vielleicht unsere Kleidung umweltfreundlich färben könnten – nachhaltig, ressourcenschonend und ohne giftige Abwässer. Lernen Sie, wie Biologie, Chemie und Kreativität zusammenwirken, um die Welt ein bisschen bunter und grüner zu machen – auf ganz natürliche Weise.
Besucherinformation
Dieser Ausstellungsstandort ist barrierefrei zugänglich und verfügt über barrierefreie Toiletten.
Öffnungszeiten
31 weitere Stationen an diesem Standort
-
MitmachstationBad Air Day – Und was atmen Sie heute?Thema: Naturwissenschaften UmweltUnd was atmen Sie heute? Viele glauben, die Luft in unseren Städten ist heutzutage sauber. In unserem Spiel mit 5 Stationen erfahren Sie, warum auch heute manchmal noch dicke Luft herrscht und was Reinigungsmittel, Asphalt, Pollen und Mini-Trampolins damit zu tun haben. Dreckige Luft ist nicht immer sichtbar, unser Leaderboard schon: Auf jene, die genügend Punkte im Spiel holen, warten ganz besondere Aerosol-Chips.Technische Universität Wien17:00 - 23:00
-
 MitmachstationGuter Schlaf und Wohlbefinden im Nachtzug – was braucht es?Thema: Energie UmweltWie könnten Nachtzüge der Zukunft innen aussehen? Der Forschungsbereich Spurgebundene Verkehrssysteme und moodley laden ein, neue Schlafabteil-Konzepte zu entdecken und zu testen. Mit Virtual-Reality und Holz-Mock-ups erleben Besuchende Ideen für mehr Komfort im Nachtzug und stimmen ab, welches Konzept überzeugt.Technische Universität Wien17:00 - 23:00 (Anmeldung erforderlich)
MitmachstationGuter Schlaf und Wohlbefinden im Nachtzug – was braucht es?Thema: Energie UmweltWie könnten Nachtzüge der Zukunft innen aussehen? Der Forschungsbereich Spurgebundene Verkehrssysteme und moodley laden ein, neue Schlafabteil-Konzepte zu entdecken und zu testen. Mit Virtual-Reality und Holz-Mock-ups erleben Besuchende Ideen für mehr Komfort im Nachtzug und stimmen ab, welches Konzept überzeugt.Technische Universität Wien17:00 - 23:00 (Anmeldung erforderlich) -
 MitmachstationKönnen kleine Organe große Wunder bewirken?Thema: Gesundheit TechnikViele Medikamente werden noch an Tieren getestet, doch Tiere reagieren oft anders als Menschen. Forschende entwickeln deshalb neue Methoden. Eine davon sind „Organ-on-a-Chips“, kleine im Labor nachgebaute Teile des menschlichen Körpers. An dieser Station wird spielerisch gezeigt, wie solche Chips entstehen – vom Entwurf bis zum Betrachten unter dem Mikroskop.Technische Universität Wien17:00 - 23:00
MitmachstationKönnen kleine Organe große Wunder bewirken?Thema: Gesundheit TechnikViele Medikamente werden noch an Tieren getestet, doch Tiere reagieren oft anders als Menschen. Forschende entwickeln deshalb neue Methoden. Eine davon sind „Organ-on-a-Chips“, kleine im Labor nachgebaute Teile des menschlichen Körpers. An dieser Station wird spielerisch gezeigt, wie solche Chips entstehen – vom Entwurf bis zum Betrachten unter dem Mikroskop.Technische Universität Wien17:00 - 23:00 -
Experiment / VorführungKönnen wir eine nachhaltige Zukunft aus atomaren Legosteinen bauen?Thema: Naturwissenschaften TechnikAm Stand der Complex Oxide Systems Group erleben Sie, wie moderne Materialforschung zu mehr Energieeffizienz beiträgt. Ultradünne Oxid-Dünnfilme ermöglichen verlustarmen Stromtransport, effiziente Datenspeicherung und neue Technologien. Entdecken Sie Vakuumtechnik, Supraleitung und magnetische Levitation – und wie Nanomaterialien nachhaltige Energie- und Computersysteme der Zukunft ermöglichen.Technische Universität Wien17:00 - 23:00
-
 MitmachstationKönnen wir mit ausrangierten Sensoren und Videospielen die Reha und Prävention revolutionieren?Thema: Digitalisierung GesundheitWie sieht die grüne Therapie der Zukunft aus? Wir entwickeln innovative Serious Games, die modernste Sensorik mit cleverem Hardware-Upcycling vereinen. Erleben Sie an unserem Parcours mit smarten Boxhandschuhen und Balance-Systemen, wie neue Software Elektroschrott vermeidet und z.B. durch Tele-Reha massiv CO2 einspart. Fit werden: für sich und den Planeten!Technische Universität Wien17:00 - 23:00
MitmachstationKönnen wir mit ausrangierten Sensoren und Videospielen die Reha und Prävention revolutionieren?Thema: Digitalisierung GesundheitWie sieht die grüne Therapie der Zukunft aus? Wir entwickeln innovative Serious Games, die modernste Sensorik mit cleverem Hardware-Upcycling vereinen. Erleben Sie an unserem Parcours mit smarten Boxhandschuhen und Balance-Systemen, wie neue Software Elektroschrott vermeidet und z.B. durch Tele-Reha massiv CO2 einspart. Fit werden: für sich und den Planeten!Technische Universität Wien17:00 - 23:00 -
 WorkshopPlanspiel: Wer glättet die Spitze?Thema: Technik UmweltBeim Planspiel „Wer glättet die Spitze?“ schlüpfen Sie in unterschiedliche Rollen von Akteuren und Akteurinnen im regionalen Schulbusverkehr einer fiktiven Region. Als solche stehen Sie vor der gemeinsamen Herausforderung, ein Schulbussystem zu gestalten, welches Klima, Kosten und gesellschaftliche Akzeptanz in Einklang bringt.Technische Universität Wien17:00 - 23:00
WorkshopPlanspiel: Wer glättet die Spitze?Thema: Technik UmweltBeim Planspiel „Wer glättet die Spitze?“ schlüpfen Sie in unterschiedliche Rollen von Akteuren und Akteurinnen im regionalen Schulbusverkehr einer fiktiven Region. Als solche stehen Sie vor der gemeinsamen Herausforderung, ein Schulbussystem zu gestalten, welches Klima, Kosten und gesellschaftliche Akzeptanz in Einklang bringt.Technische Universität Wien17:00 - 23:00 -
 AusstellungSind traditionelle Baustoffe noch zeitgemäß?Thema: Technik UmweltNachwachsende Rohstoffe (NAWAROS) als Grundlage für Bau- und Verbundmaterialien in der Industrie sind trotz klarer Vorteile bei Nachhaltigkeit und geringeren Emissionen weiterhin ein Nischenbereich. Wir holen diese Stoffe vor den Vorhang und präsentieren konkrete, langjährig erprobte Anwendungsbeispiele für NAWAROS in Bauwirtschaft und Industrie.Technische Universität Wien17:00 - 23:00
AusstellungSind traditionelle Baustoffe noch zeitgemäß?Thema: Technik UmweltNachwachsende Rohstoffe (NAWAROS) als Grundlage für Bau- und Verbundmaterialien in der Industrie sind trotz klarer Vorteile bei Nachhaltigkeit und geringeren Emissionen weiterhin ein Nischenbereich. Wir holen diese Stoffe vor den Vorhang und präsentieren konkrete, langjährig erprobte Anwendungsbeispiele für NAWAROS in Bauwirtschaft und Industrie.Technische Universität Wien17:00 - 23:00 -
MitmachstationSmartBeetle: Was riecht der Borkenkäfer – und kann KI ihn überlisten?Thema: Naturwissenschaften UmweltAn der SMARTbeetle-Station werden umweltfreundliche Strategien gegen den Borkenkäfer vorgestellt, dessen Ausbreitung durch Klimawandel und Trockenstress zunimmt. Besuchende erfahren, wie künstliche Intelligenz Duftstoffe und ihre Wirkung analysiert, um nachhaltige Lockstoffe als Alternative zu Pestiziden zu entwickeln. Mitmachspiele sowie Geruchs- und Fühlstationen laden zum Entdecken ein.Technische Universität Wien17:00 - 23:00
-
 MitmachstationSonne im Miniaturformat: Nachhaltige Energie, aber wie?Thema: Energie NaturwissenschaftenWas wäre, wenn wir mit einer Mini-Sonne Strom generieren? Saubere, nachhaltige Energie, ohne fossile Brennstoffe? Dies geschieht bereits in Testreaktoren weltweit, aber es hat einen Haken: Die hochenergetischen Teilchen fressen die Reaktorwände an! An dieser Station lernen Sie spielerisch, was im Material passiert, wenn Teilchen auf eine Oberfläche prallen.Technische Universität Wien17:00 - 23:00
MitmachstationSonne im Miniaturformat: Nachhaltige Energie, aber wie?Thema: Energie NaturwissenschaftenWas wäre, wenn wir mit einer Mini-Sonne Strom generieren? Saubere, nachhaltige Energie, ohne fossile Brennstoffe? Dies geschieht bereits in Testreaktoren weltweit, aber es hat einen Haken: Die hochenergetischen Teilchen fressen die Reaktorwände an! An dieser Station lernen Sie spielerisch, was im Material passiert, wenn Teilchen auf eine Oberfläche prallen.Technische Universität Wien17:00 - 23:00 -
 AusstellungStromfresser oder Klimaretter? Computer und die Zukunft unserer Umwelt.Thema: Digitalisierung EnergieWir widmen uns dem Ressourcenverbrauch digitaler Infrastruktur: Wie viel Strom braucht ein Computer – und wie viel erst KI? Gleichzeitig zeigen wir, wie KI selbst zur Lösung werden kann: von nachhaltiger Landwirtschaft bis zur Digitalisierung am Hof, etwa durch digitale Kuhglocken, die die Arbeit von Landwirten und Landwirtinnen deutlich erleichtern.Technische Universität Wien17:00 - 23:00
AusstellungStromfresser oder Klimaretter? Computer und die Zukunft unserer Umwelt.Thema: Digitalisierung EnergieWir widmen uns dem Ressourcenverbrauch digitaler Infrastruktur: Wie viel Strom braucht ein Computer – und wie viel erst KI? Gleichzeitig zeigen wir, wie KI selbst zur Lösung werden kann: von nachhaltiger Landwirtschaft bis zur Digitalisierung am Hof, etwa durch digitale Kuhglocken, die die Arbeit von Landwirten und Landwirtinnen deutlich erleichtern.Technische Universität Wien17:00 - 23:00 -
 KinderprogrammTU Transformer: Wie wird aus Technik Zukunft und aus Altem etwas Neues?Thema: Technik UmweltHier wird ausprobiert, gebaut und gestaunt: Strom lässt sich kneten, einfache Stromkreise entstehen, und technische Grundlagen werden spielerisch begreifbar. Aus alten T-Shirts wächst ein Zelt – Upcycling zum Anfassen. Mit Mitmachkoffern und Bauideen wie einem kreislauffähigen Hocker wird Nachhaltigkeit kreativ erlebbar.Technische Universität Wien17:00 - 23:00
KinderprogrammTU Transformer: Wie wird aus Technik Zukunft und aus Altem etwas Neues?Thema: Technik UmweltHier wird ausprobiert, gebaut und gestaunt: Strom lässt sich kneten, einfache Stromkreise entstehen, und technische Grundlagen werden spielerisch begreifbar. Aus alten T-Shirts wächst ein Zelt – Upcycling zum Anfassen. Mit Mitmachkoffern und Bauideen wie einem kreislauffähigen Hocker wird Nachhaltigkeit kreativ erlebbar.Technische Universität Wien17:00 - 23:00 -
 Experiment / VorführungVom Meeresboden bis in den Weltraum – Wie beobachten wir unser System Erde?Thema: Naturwissenschaften UmweltZur Langen Nacht der Forschung bringen wir spannende Experimente und Beispiele aus unserer Arbeit mit. Wir zeigen, wie Satelliten die Erde beobachten und wie sich damit Prozesse wie der Klimawandel sichtbar machen lassen. Neben Bildern aus dem All zeigen wir Messungen an der Oberfläche, die eindrucksvolle Einblicke in Wälder und Meere geben – und bringen sogar Permafrost aus den Alpen für Experimente nach Wien.Technische Universität Wien17:00 - 23:00
Experiment / VorführungVom Meeresboden bis in den Weltraum – Wie beobachten wir unser System Erde?Thema: Naturwissenschaften UmweltZur Langen Nacht der Forschung bringen wir spannende Experimente und Beispiele aus unserer Arbeit mit. Wir zeigen, wie Satelliten die Erde beobachten und wie sich damit Prozesse wie der Klimawandel sichtbar machen lassen. Neben Bildern aus dem All zeigen wir Messungen an der Oberfläche, die eindrucksvolle Einblicke in Wälder und Meere geben – und bringen sogar Permafrost aus den Alpen für Experimente nach Wien.Technische Universität Wien17:00 - 23:00 -
 AusstellungWarum ökosozial sanieren – und wie?Thema: Technik UmweltBis zu 40 % der CO₂-Emissionen in Österreich entstehen durch Bau und Betrieb von Gebäuden. Unser Konzept zur ökosozialen Sanierung von Wohnhausanlagen reduziert diese Emissionen und verbessert Gebäude, Grünräume und Mobilität ganzheitlich. Auf Basis der Publikation „Zukunft Bestand“ und aktueller Forschung zeigt die Station Bilder, Pläne, Grafiken sowie ein Modell zur ökosozialen Transformation.Technische Universität Wien17:00 - 23:00
AusstellungWarum ökosozial sanieren – und wie?Thema: Technik UmweltBis zu 40 % der CO₂-Emissionen in Österreich entstehen durch Bau und Betrieb von Gebäuden. Unser Konzept zur ökosozialen Sanierung von Wohnhausanlagen reduziert diese Emissionen und verbessert Gebäude, Grünräume und Mobilität ganzheitlich. Auf Basis der Publikation „Zukunft Bestand“ und aktueller Forschung zeigt die Station Bilder, Pläne, Grafiken sowie ein Modell zur ökosozialen Transformation.Technische Universität Wien17:00 - 23:00 -
MitmachstationWas haben Erdäpfel und Batterien gemeinsam?Thema: Energie NaturwissenschaftenWir folgen dem Weg des Stroms – vom Erdapfel als Batterie bis zur nachhaltigen Energie im Haus. Mit Rotkrautsaft machen wir chemische Prozesse sichtbar, messen Spannungen, verkabeln Stromkreise und entdecken, wie Batterien funktionieren. Mit Sammelpass geht’s durch die Stationen und hinein ins Forschungslabor. Machen Sie sich mit uns auf die Reise durch die Welt der Energie!Technische Universität Wien17:00 - 23:00
-
 MitmachstationWas ist dein(e) Q?Thema: GesellschaftEntdecken Sie das "Q. Dein Raum für Wissenschaft." Ein Ort, der Ihre Fragen ernst nimmt: aktuelle Forschung trifft auf Alltag – interaktiv, inspirierend, vielseitig. Lernen Sie das Projekt und die Forschenden der drei Betreiberorganisationen ÖAW, TU Wien und Uni Wien kennen und erfahren Sie, was sie antreibt. Die Türen öffnen 2027 – der Dialog startet jetzt. Werden Sie Teil der Community und gestalten Sie das Q mit!Technische Universität Wien17:00 - 23:00
MitmachstationWas ist dein(e) Q?Thema: GesellschaftEntdecken Sie das "Q. Dein Raum für Wissenschaft." Ein Ort, der Ihre Fragen ernst nimmt: aktuelle Forschung trifft auf Alltag – interaktiv, inspirierend, vielseitig. Lernen Sie das Projekt und die Forschenden der drei Betreiberorganisationen ÖAW, TU Wien und Uni Wien kennen und erfahren Sie, was sie antreibt. Die Türen öffnen 2027 – der Dialog startet jetzt. Werden Sie Teil der Community und gestalten Sie das Q mit!Technische Universität Wien17:00 - 23:00 -
AusstellungWas passiert mit CO₂ – und wie können wir es nutzen?Thema: Technik UmweltDie Station vermittelt interaktiv Grundlagen zu Herkunft, Emission und Nutzung von CO₂ aus fossilen Energieträgern. Entlang der CO₂-Prozesskette werden Herausforderungen der Umwandlung, der Einsatz von Biomasse als Rohstoff sowie aktuelle Forschungsansätze zur chemischen Umwandlung von CO₂ in Wertstoffe vorgestellt.Technische Universität Wien17:00 - 23:00
-
 MitmachstationWelche Rolle spielen Algorithmen in einer Welt voller Informatik und KI?Thema: DigitalisierungAn der interaktiven Mitmachstation vom TU Wien Informatics eduLAB können Interessierte mit Unplugged-Materialien, d.h. ohne Einsatz von Computern, die Welt der Algorithmen entdecken. Interessierte aller Altersstufen erfahren hier durch spielerische Aktivitäten wie Algorithmen funktionieren und welche Rolle sie in einer nachhaltigen Welt voller Informatik und künstlicher Intelligenz spielen.Technische Universität Wien17:00 - 23:00
MitmachstationWelche Rolle spielen Algorithmen in einer Welt voller Informatik und KI?Thema: DigitalisierungAn der interaktiven Mitmachstation vom TU Wien Informatics eduLAB können Interessierte mit Unplugged-Materialien, d.h. ohne Einsatz von Computern, die Welt der Algorithmen entdecken. Interessierte aller Altersstufen erfahren hier durch spielerische Aktivitäten wie Algorithmen funktionieren und welche Rolle sie in einer nachhaltigen Welt voller Informatik und künstlicher Intelligenz spielen.Technische Universität Wien17:00 - 23:00 -
 MitmachstationWie formen Elektrizität und Magnetismus unseren Alltag?Thema: Energie TechnikBei der Station ‚Elektromagnetismus‘ wird mit dem Magneten eines Dynamos mit den eigenen Händen ‚grüner‘ elektrischer Strom generiert. Auch thermoelektrische Elemente und Wirbelstrombremsen werden selbst ausgetestet. Zudem werden Tieftemperatureffekte (flüssiger Stickstoff!) demonstriert und ein Magnet mit Feuer ‚ausgeschaltet‘. Wer gerne mit Feuer spielt und Hochspannung am eigenen Leib erfährt, ist hier richtig!Technische Universität Wien17:00 - 23:00
MitmachstationWie formen Elektrizität und Magnetismus unseren Alltag?Thema: Energie TechnikBei der Station ‚Elektromagnetismus‘ wird mit dem Magneten eines Dynamos mit den eigenen Händen ‚grüner‘ elektrischer Strom generiert. Auch thermoelektrische Elemente und Wirbelstrombremsen werden selbst ausgetestet. Zudem werden Tieftemperatureffekte (flüssiger Stickstoff!) demonstriert und ein Magnet mit Feuer ‚ausgeschaltet‘. Wer gerne mit Feuer spielt und Hochspannung am eigenen Leib erfährt, ist hier richtig!Technische Universität Wien17:00 - 23:00 -
Experiment / VorführungWie funktionieren Reaktionen auf einem Nanopartikel?Thema: Energie NaturwissenschaftenIn Zeiten, in denen erneuerbare Energien immer relevanter werden, spielt Wasserstoff eine besondere Rolle. Er wird katalytisch zu Wasser umgesetzt, um Energie zu gewinnen. Doch wie funktioniert diese Reaktion und wie lässt sie sich am Katalysator beobachten? Genau das zeigen wir an unserer Station anhand eines lebensgroßen Modells eines katalytischen Nanopartikels.Technische Universität Wien17:00 - 23:00
-
 Experiment / VorführungWie helfen uns Oberflächen bei der effizienten Energienutzung?Thema: Energie NaturwissenschaftenAn dieser Station wird ein „atomistisches“ Bild von Oberflächen mit einem einfachen Modell vermittelt. In einem aufblasbaren Pool werden Plastikkugeln wie Atome in einem Gitter angeordnet. So entstehen glatte Flächen, Kanten und Stufen wie auf echten Kristalloberflächen. Besucherinnen und Besucher sehen, wie Oberflächen im Kleinen aufgebaut sind und warum sie nicht perfekt glatt sind.Technische Universität Wien17:00 - 23:00
Experiment / VorführungWie helfen uns Oberflächen bei der effizienten Energienutzung?Thema: Energie NaturwissenschaftenAn dieser Station wird ein „atomistisches“ Bild von Oberflächen mit einem einfachen Modell vermittelt. In einem aufblasbaren Pool werden Plastikkugeln wie Atome in einem Gitter angeordnet. So entstehen glatte Flächen, Kanten und Stufen wie auf echten Kristalloberflächen. Besucherinnen und Besucher sehen, wie Oberflächen im Kleinen aufgebaut sind und warum sie nicht perfekt glatt sind.Technische Universität Wien17:00 - 23:00 -
Experiment / VorführungWie kann die Oberflächenforschung zur Nachhaltigkeit beitragen?Thema: Naturwissenschaften TechnikAn unserer Station zeigen wir, wie wir mit modernen Methoden Materialoberflächen untersuchen. So können wir ihren atomaren Aufbau sichtbar machen und verstehen, welche chemischen und physikalischen Prozesse sie für verschiedene Anwendungen besonders interessant machen. Auf dieser Basis entwickeln wir präzise Modelle der Materialien.Technische Universität Wien17:00 - 23:00
-
 Experiment / VorführungWie kann man aus Sonnenlicht Wasserstoffenergie gewinnen?Thema: Energie NaturwissenschaftenAn unserer Station wird gezeigt, wie Sonnenlicht und Wasser in direkten (Photokatalyse) und indirekten Systemen (Solarzelle und Elektrolyse) zu grünem Wasserstoff umgewandelt werden. Veranschaulicht werden die Spaltung von H₂O in H₂ und O₂ sowie ein innovatives Katalysatordesign für die einstufige Wasserstoffproduktion aus Wasser.Technische Universität Wien17:00 - 23:00
Experiment / VorführungWie kann man aus Sonnenlicht Wasserstoffenergie gewinnen?Thema: Energie NaturwissenschaftenAn unserer Station wird gezeigt, wie Sonnenlicht und Wasser in direkten (Photokatalyse) und indirekten Systemen (Solarzelle und Elektrolyse) zu grünem Wasserstoff umgewandelt werden. Veranschaulicht werden die Spaltung von H₂O in H₂ und O₂ sowie ein innovatives Katalysatordesign für die einstufige Wasserstoffproduktion aus Wasser.Technische Universität Wien17:00 - 23:00 -
 Experiment / VorführungWie kann unser Abwasser von Arzneimittelrückständen und Haushaltschemikalien gereinigt werden?Thema: Technik UmweltWir setzen in unserem Alltag immer mehr Chemikalien ein, z. B. als Medikamente, Haushaltschemikalien und für die Körperpflege. Aufgrund dieser immer komplexeren Zusammensetzung des Abwassers müssen Kläranlagen zukünftig über eine vierte Reinigungsstufe verfügen um diese Substanzen zu entfernen. Es werden Technologien mit Ozon oder Aktivkohle demonstriert, die an der TU Wien mit entwickelt und untersucht werden.Technische Universität Wien17:00 - 23:00
Experiment / VorführungWie kann unser Abwasser von Arzneimittelrückständen und Haushaltschemikalien gereinigt werden?Thema: Technik UmweltWir setzen in unserem Alltag immer mehr Chemikalien ein, z. B. als Medikamente, Haushaltschemikalien und für die Körperpflege. Aufgrund dieser immer komplexeren Zusammensetzung des Abwassers müssen Kläranlagen zukünftig über eine vierte Reinigungsstufe verfügen um diese Substanzen zu entfernen. Es werden Technologien mit Ozon oder Aktivkohle demonstriert, die an der TU Wien mit entwickelt und untersucht werden.Technische Universität Wien17:00 - 23:00 -
 FührungWie können Stahl und Flugzeuge klimafreundlicher werden?Thema: Energie TechnikDiese Führung zeigt, wie Forschung CO₂-intensive Industrien wie Stahlproduktion und Luftfahrt nachhaltiger macht. Anhand realer Anlagen, Modelle und Demonstratoren erleben Besuchende, wie Biomasse, Wasserstoff in Kombination mit Brennstoffzellen, Elektromotoren und innovative Getriebe helfen, Emissionen zu senken und die Industrie der Zukunft zu gestalten.Technische Universität Wien17:00 - 23:00
FührungWie können Stahl und Flugzeuge klimafreundlicher werden?Thema: Energie TechnikDiese Führung zeigt, wie Forschung CO₂-intensive Industrien wie Stahlproduktion und Luftfahrt nachhaltiger macht. Anhand realer Anlagen, Modelle und Demonstratoren erleben Besuchende, wie Biomasse, Wasserstoff in Kombination mit Brennstoffzellen, Elektromotoren und innovative Getriebe helfen, Emissionen zu senken und die Industrie der Zukunft zu gestalten.Technische Universität Wien17:00 - 23:00 -
AusstellungWie können wir den Klimawandel abmildern?Thema: Naturwissenschaften UmweltUnser Energieverbrauch steigt – und damit auch der CO2-Ausstoß. Obwohl erneuerbare Energien immer wichtiger werden, bleiben Emissionen vorerst unvermeidbar. Eine mögliche Lösung: CO2 tief unter der Erde speichern. In Experimenten und Supercomputer-Simulationen erforschen wir, wie sich CO2 in Gestein verhält – für sichere Technologien im Kampf gegen den Klimawandel.Technische Universität Wien17:00 - 23:00
-
 MitmachstationWie können wir in Zukunft nachhaltig mobil sein?Thema: Energie TechnikErleben Sie nachhaltige Mobilität hautnah. Erraten Sie (außer)gewöhnliche Gründe für die Autonutzung, testen Sie das „Gehzeug“ oder nehmen Sie live bei unserer Modal Split Erhebung teil. Analysieren Sie die Platzverteilung im öffentlichen Raum mit Legosteinen sowie dem StreetTUner & machen die Stadt mit uns cycleFIT. Ein interaktiver Einblick in unseren Verkehrs(forschungs)alltag und die Flächenverteilung der Stadt.Technische Universität Wien17:00 - 23:00
MitmachstationWie können wir in Zukunft nachhaltig mobil sein?Thema: Energie TechnikErleben Sie nachhaltige Mobilität hautnah. Erraten Sie (außer)gewöhnliche Gründe für die Autonutzung, testen Sie das „Gehzeug“ oder nehmen Sie live bei unserer Modal Split Erhebung teil. Analysieren Sie die Platzverteilung im öffentlichen Raum mit Legosteinen sowie dem StreetTUner & machen die Stadt mit uns cycleFIT. Ein interaktiver Einblick in unseren Verkehrs(forschungs)alltag und die Flächenverteilung der Stadt.Technische Universität Wien17:00 - 23:00 -
 MitmachstationWie macht die Physik Regenbögen auf Schokolade? Und was hat das mit Sonnenblumen zu tun?Thema: Technik UmweltVon Gelb zu Gold zum Regenbogen: Diese Mitmachstation zeigt, wie Farben physikalisch und chemisch entstehen – von goldenen Nanopartikeln aus Pflanzen über gelbe Sonnenblumenpigmente bis zu schillernden Strukturfarben. Wir zaubern essbare Regenbögen auf Schokolade, färben den Morpho-Schmetterling grüngolden und entdecken, wie Material, Struktur und Farbe zusammenhängen.Technische Universität Wien17:00 - 23:00
MitmachstationWie macht die Physik Regenbögen auf Schokolade? Und was hat das mit Sonnenblumen zu tun?Thema: Technik UmweltVon Gelb zu Gold zum Regenbogen: Diese Mitmachstation zeigt, wie Farben physikalisch und chemisch entstehen – von goldenen Nanopartikeln aus Pflanzen über gelbe Sonnenblumenpigmente bis zu schillernden Strukturfarben. Wir zaubern essbare Regenbögen auf Schokolade, färben den Morpho-Schmetterling grüngolden und entdecken, wie Material, Struktur und Farbe zusammenhängen.Technische Universität Wien17:00 - 23:00 -
 WorkshopWie viel Raum steckt in einem Stück recycelter Folie?Thema: Gesellschaft TechnikErleben Sie, wie aus hauchdünner, recycelter PE-Folie ganze Räume entstehen. Bauen Sie selbst mit einfachen Alltagsmaterialien eine kleine Membranstruktur und entdecken Sie, wie wenig es braucht, um Raum zu formen. Gleichzeitig zeigen wir eine große aufblasbare Installation, die mit minimalem Materialeinsatz maximale Wirkung erzielt – nachhaltig, spielerisch und für alle offen.Technische Universität Wien17:00 - 23:00
WorkshopWie viel Raum steckt in einem Stück recycelter Folie?Thema: Gesellschaft TechnikErleben Sie, wie aus hauchdünner, recycelter PE-Folie ganze Räume entstehen. Bauen Sie selbst mit einfachen Alltagsmaterialien eine kleine Membranstruktur und entdecken Sie, wie wenig es braucht, um Raum zu formen. Gleichzeitig zeigen wir eine große aufblasbare Installation, die mit minimalem Materialeinsatz maximale Wirkung erzielt – nachhaltig, spielerisch und für alle offen.Technische Universität Wien17:00 - 23:00 -
 FührungWie werden Batterien nachhaltig – und CO₂ plötzlich wertvoll?Thema: Energie UmweltBei einer Tour durch die Chemielabors der TU Wien gibt es zwei Stationen: Zuerst die Sauerstoffionenbatterie – sie besteht aus nachhaltigen Materialien, ist nicht brennbar und gilt als vielversprechend für die stationäre Stromspeicherung. Danach der Bioreaktor: Dort wandeln genetisch veränderte Bakterien CO₂ in den wertvollen Rohstoff Formiat um.Technische Universität Wien17:00 - 23:00
FührungWie werden Batterien nachhaltig – und CO₂ plötzlich wertvoll?Thema: Energie UmweltBei einer Tour durch die Chemielabors der TU Wien gibt es zwei Stationen: Zuerst die Sauerstoffionenbatterie – sie besteht aus nachhaltigen Materialien, ist nicht brennbar und gilt als vielversprechend für die stationäre Stromspeicherung. Danach der Bioreaktor: Dort wandeln genetisch veränderte Bakterien CO₂ in den wertvollen Rohstoff Formiat um.Technische Universität Wien17:00 - 23:00 -
 Experiment / VorführungWie wird man Chemiker:in?Thema: NaturwissenschaftenLust auf ein Studium mit Impact? Im Praktikumshörsaal der TU Wien zeigen wir, wie man als Chemiker:in oder Verfahrenstechniker:in echte Lösungen für die Welt von morgen entwickelt. Ihr Weg vom Klassenzimmer in die Spitzenforschung beginnt hier!Technische Universität Wien17:00 - 23:00
Experiment / VorführungWie wird man Chemiker:in?Thema: NaturwissenschaftenLust auf ein Studium mit Impact? Im Praktikumshörsaal der TU Wien zeigen wir, wie man als Chemiker:in oder Verfahrenstechniker:in echte Lösungen für die Welt von morgen entwickelt. Ihr Weg vom Klassenzimmer in die Spitzenforschung beginnt hier!Technische Universität Wien17:00 - 23:00 -
 Experiment / VorführungWieso macht Strom Metalle bunt?Thema: Energie Naturwissenschaften„Gott schuf das Volumen, der Teufel die Oberfläche“ (W. Pauli) – klassische Modelle beschreiben Oberflächen oft unzureichend, obwohl sie Materialeigenschaften wie Energiespeicherung, Katalyse oder Korrosion bestimmen. An unserer Station wird gezeigt, wie sich Metalloberflächen mit Strom gezielt verändern lassen – und welche farbenfrohen Effekte dabei entstehen.Technische Universität Wien17:00 - 23:00
Experiment / VorführungWieso macht Strom Metalle bunt?Thema: Energie Naturwissenschaften„Gott schuf das Volumen, der Teufel die Oberfläche“ (W. Pauli) – klassische Modelle beschreiben Oberflächen oft unzureichend, obwohl sie Materialeigenschaften wie Energiespeicherung, Katalyse oder Korrosion bestimmen. An unserer Station wird gezeigt, wie sich Metalloberflächen mit Strom gezielt verändern lassen – und welche farbenfrohen Effekte dabei entstehen.Technische Universität Wien17:00 - 23:00